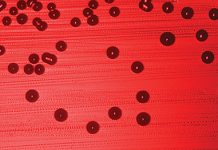
SEPSA – co kosmetolog wiedzieć powinien

KOSMETOLOGIA I MEDYCYNA ESTETYCZNA
Historia opisuje poszukiwania kosmetyków, eliksirów, specyfików mogących uczynić nas pięknymi, czy wręcz pokonać śmierć. Dziś wiemy, że możemy co najwyżej opóźniać pewne procesy i w tym...
Lasery i pierwsze ich zastosowania w dermatologii i kosmetologii
1917
Twórcą teorii promieniowania laserowego był znany wszystkim genialny fizyk - Albert Einstein. Miało to miejsce blisko 100 lat temu,
bo w 1917 roku. Urzeczywistnienie jego przemyśleń i analiz...
Ocena zmian barwnikowych i metody ich usuwania
Streszczenie
Zmiany barwnikowe są wynikiem aktywowania melanocytów (melanosis) lub zwiększonej liczby melanocytów (melanocytosis). Czynnikiem mającym największy wpływ na indukowanie procesu melanogenezy jest promieniowanie ultrafioletowe. Zmiany barwnikowe, obok zmarszczek, są czynnikami, które...
Przeszczepy włosów
Wypadanie włosów to coraz powszechniejszy problem – głównie, choć nie wyłącznie, dla mężczyzn. Przyczyny tego zjawiska są mocno
zróżnicowane, szeroki też jest wachlarz potencjalnych rozwiązań profilaktycznych. Gabinety kosmetyczne oraz...
Kształtowanie sylwetki metodą liposukcji – przegląd dostępnych metod inwazyjnych i nieinwazyjnych
Liposukcja to od wielu już lat jeden z najpopularniejszych zabiegów chirurgicznych w medycynie estetycznej. Co roku korzysta z niego
ponad pół miliona Amerykanek. Fraza ta jest też bardzo...
SEPSA – co kosmetolog wiedzieć powinien
Streszczenie
Sepsa, inaczej posocznica, budzi wśród ludzi lęk. Często mylona jest z innymi rodzajami zakażeń, np. bakteriemią. Od 1991 roku funkcjonują ściśle określone definicje i kryteria rozpoznania sepsy. Ze...
Rola lamelarnych warstw lipidowych w procesie przenikania substancji przez skórę
Streszczenie
Proces przenikania substancji leczniczych i kosmetycznych przez skórę jest zdeterminowany budową warstwy rogowej naskórka. W jego powierzchniowej części, pomiędzy ściśle do siebie przylegającymi martwymi komórkami, zwanymi keratynocytami, występuje macierz...
Zgoda na zabieg
Czy osoba niepełnoletnia może sama decydować o wyglądzie swojego ciała?
Dopuszczalność zabiegów kosmetycznych nie budzi wątpliwości, nawet jeśli ich przejściowym efektem jest uszkodzenie ciała czy pogorszenie wyglądu. Jednak...